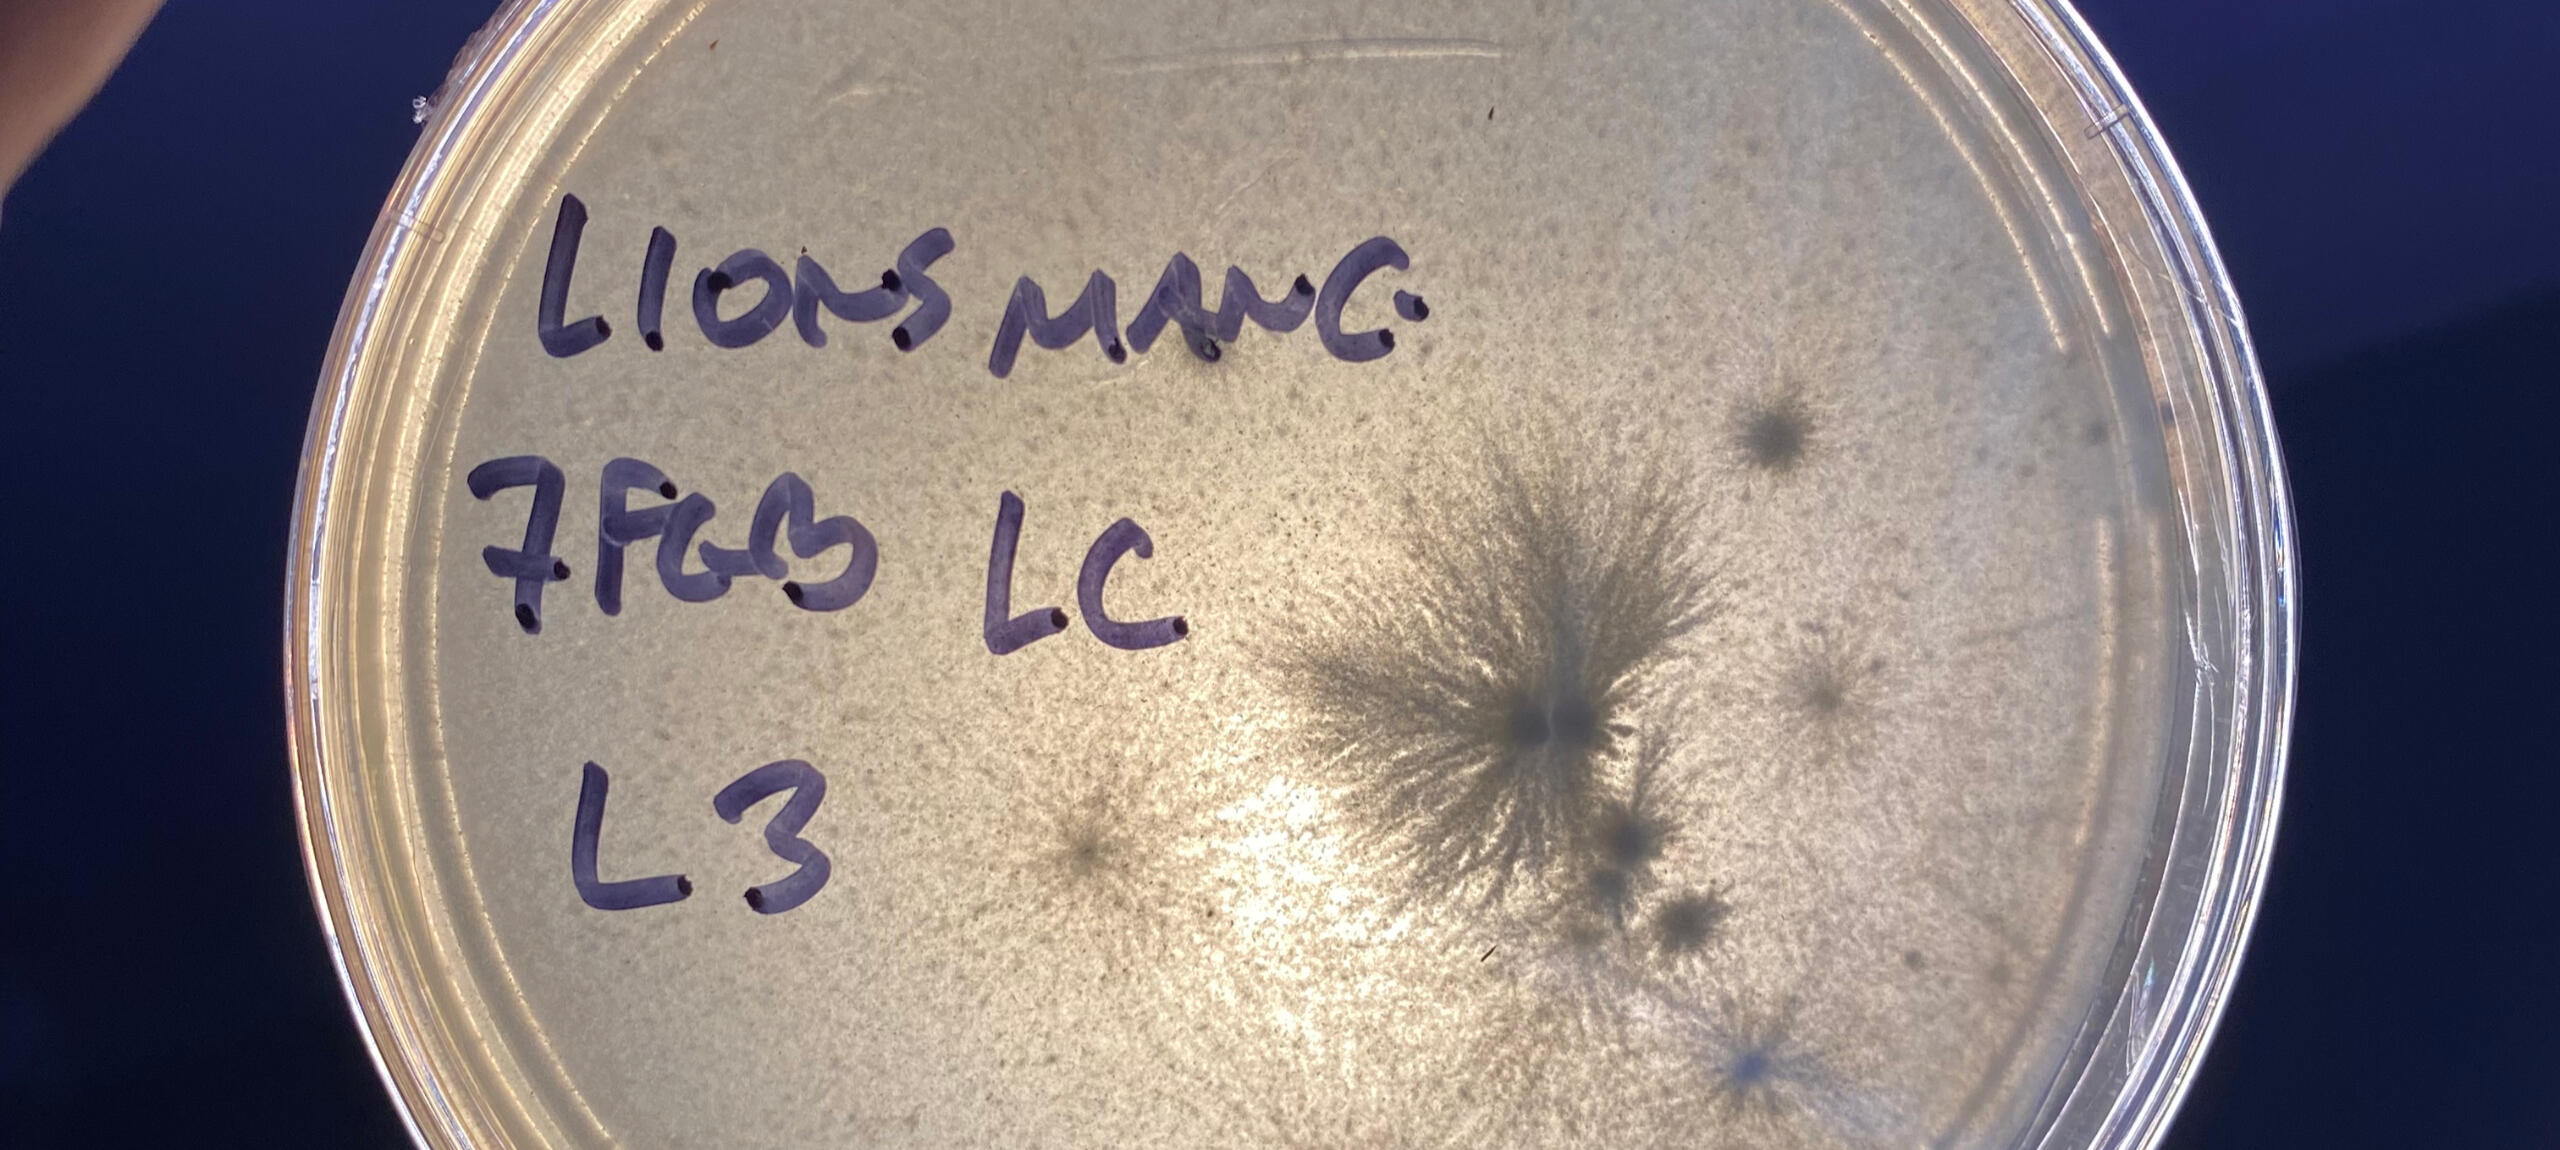

Brew. Reuse. Renew.
Rebrewal Organics
Transforming our brewed resources into sustainable food, medicine, and more!

It's What we do
A waste recovery project designed by Alan Henderson, an 11-year Army veteran from Clearwater, as way to address the estimated 12,342 lbs of commercial coffee waste generated EVERYDAY in Pinellas County. Enough to make 339,293 cups of coffee. Now that's some serious JOE!Spearheaded by Fungal Effect Mushroom Co., they have developed a system to recover that precious organic material BEFORE it's locked away forever in landfill.We seek to demonstrate our effort serve as a model for sustainable environmental stewardship. Repurposing organic waste into nourishing products is a way we can give back to the community.

They've developed a proprietary system to repurpose coffee and other agricultural waste into nutrient-rich culinary mushrooms, powerful medicines, regenerative soil, fuel products, and more on a GRAND SCALE!!!That waste is collected, repurposed, and transformed into beautiful, gourmet and medicinal mushrooms and their products.

How It Works
☕ Collect – We partner with local cafés to recover their used coffee grounds
🍄Transform – The grounds are used by fungi to produce mushrooms and mushroom products
🌍 Return – Products go back into the community—less waste, more nourishment

Full Life Cycle
Impact in Action
Countup
5,123lbs (=140,882 brews recovered)Since April 2025, Fungal Effect Mushroom Co., has been directly responsible for the recovery and cultivation of the above weight, and we're just getting started!OUR GOAL:
Design and implement strategies and infrastructure to support the recovery of various commercial organics to reduce, repurpose, and reshape how we preserve our resources through the full life cycle.-Recover and repurpose >1 MILLION CUPS (37,307lbs) of coffee waste back into the community on or before
01JUNE2026.
Percent complete: 11.91%
Countdown

Get Involved
Join the Groundswell
Our ultimate goal is to repurpose 100% of all coffee grounds brewed in Pinellas County, FL. This project is loaded with potential and is making a HUGE impact on the community!Help support the movement on the road to ZERO waste.Questions?
Send us an email and eliminate your organic waste footprint.Partner with Us | Shop NowDonate